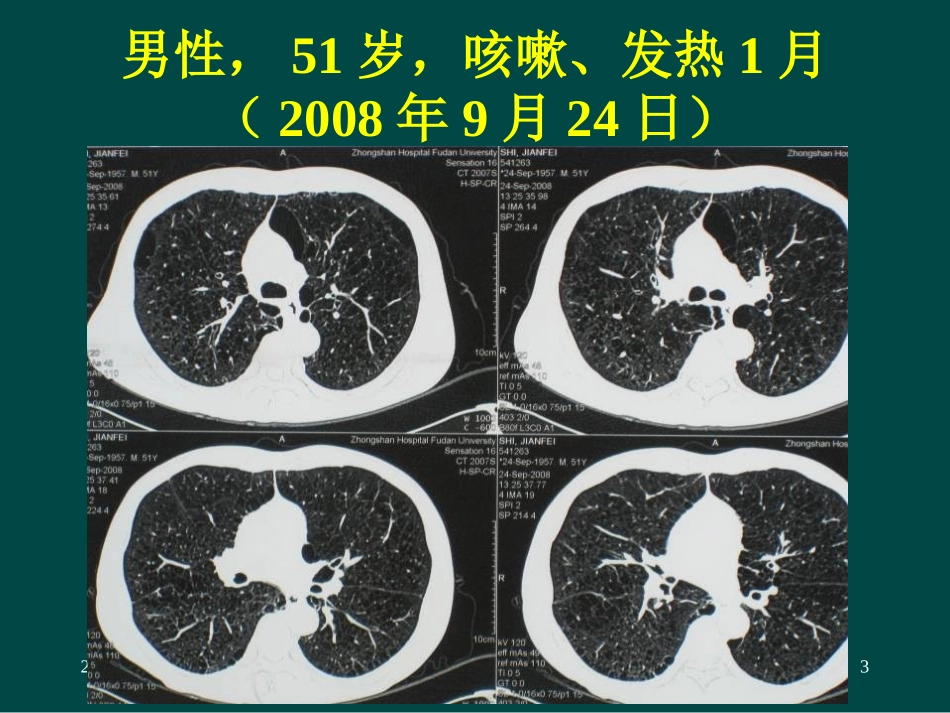
肺真菌感染的诊断进展与治疗疗效_第3页

24/12/25Dr
HUBijie1肺真菌病肺真菌病诊断与治疗进展复旦大学附属中山医院胡必杰24/12/25Dr
HUBijie2肺部真菌病临床上真的很常见吗
24/12/25Dr
HUBijie3男性,51岁,咳嗽、发热1月(2008年9月24日)24/12/25Dr
HUBijie410月19日病情明显进展24/12/25Dr
HUBijie511月3日,CT示病灶继续发展症状仍为咳嗽,低热24/12/25Dr
HUBijie6【病例】两肺结节伴空洞•男,59岁,1周前受凉后出现咳嗽、少量白痰,伴畏寒、发热,38
4C,无胸痛、咯血
•胸部CT示“两肺弥漫性肺癌
”,•2006年10月17日支气管镜检查后入院
•既往无体健,吸烟史30支/天×40年
24/12/25Dr
HUBijie724/12/25Dr
HUBijie8两肺弥漫性结节影,考虑特异性感染(真菌或结核)可能大,MT不除外24/12/25Dr
HUBijie9•纤支镜:各支气管管腔通畅,右下叶背段管口见少许白色分泌物,右上叶前段活检肺组织六块•肺组织真菌涂片找见烟曲霉菌丝、孢子
5*10^9/L,N62
4%;ESR:36mm/H;•血糖:20+mmol/L•血GM(2006-10-27):1
3124/12/25Dr
HUBijie101468143341541024681012141618202002200320042005200620072008(1-3m)年份例数寄生性侵袭性中山医院54例肺曲霉病临床分析:年份分布24/12/25Dr
HUBijie11中山医院54例肺曲霉病临床分析:科室分布24/12/25Dr
HUBijie1215例侵袭性肺曲霉病曲霉种类构成图•烟曲霉12例•黄曲霉2例•烟曲霉和黄曲霉1例24/12/25Dr
HUBijie1342例非AIDS患者肺隐球菌病影像